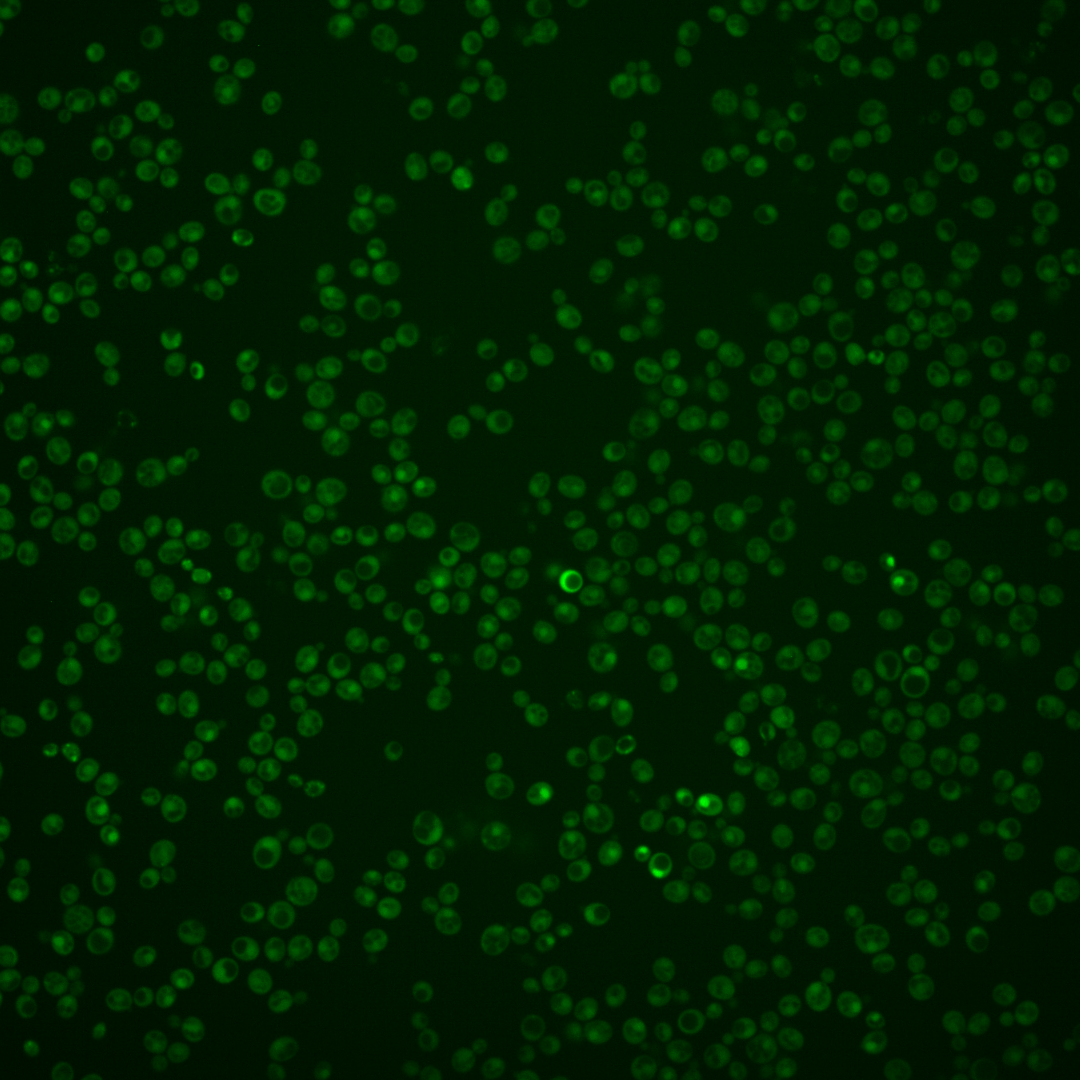

| Standard name | |
|---|---|
| Human Ortholog | |
| Description | Minor isoform of pyruvate decarboxylase; key enzyme in alcoholic fermentation, decarboxylates pyruvate to acetaldehyde, regulation is glucose- and ethanol-dependent, repressed by thiamine, involved in amino acid catabolism |
Micrographs




















































































Sub-cellular Localization
Yeast GFP Assignment
Protein Abundance
Localization Change
External localization resources
| ensLOC | DeepLoc | |||||||||||||||||||||||
|---|---|---|---|---|---|---|---|---|---|---|---|---|---|---|---|---|---|---|---|---|---|---|---|---|
| Localization | WT1 | WT2 | WT3 | RAP60 | RAP140 | RAP220 | RAP300 | RAP380 | RAP460 | RAP540 | RAP620 | RAP700 | HU80 | HU120 | HU160 | rpd3Δ_1 | rpd3Δ_2 | rpd3Δ_3 | WT1 | WT2 | WT3 | AF100 | AF140 | AF180 |
| Cortical Patches | 0 | 0 | 0 | 0 | 0 | 0 | 1 | – | 0 | 1 | 0 | 0 | 0 | 0 | 0 | 0 | 0 | 0 | 1 | 1 | 3 | 0 | 0 | 0 |
| Bud | 0 | 0 | 0 | 0 | 0 | 2 | 4 | – | 6 | 2 | 7 | 6 | 0 | 0 | 0 | 0 | 0 | 0 | 6 | 4 | 1 | 0 | 0 | 0 |
| Bud Neck | 0 | 1 | 2 | 5 | 7 | 4 | 12 | – | 7 | 9 | 4 | 14 | 0 | 0 | 0 | 0 | 0 | 0 | 3 | 1 | 2 | 0 | 0 | 0 |
| Bud Site | 0 | 0 | 0 | 0 | 0 | 1 | 0 | – | 1 | 1 | 4 | 1 | 0 | 0 | 0 | 0 | 0 | 0 | – | – | – | – | – | – |
| Cell Periphery | 0 | 1 | 0 | 2 | 0 | 1 | 4 | – | 0 | 3 | 3 | 2 | 0 | 0 | 0 | 2 | 3 | 1 | 0 | 0 | 2 | 0 | 0 | 0 |
| Cytoplasm | 201 | 180 | 170 | 304 | 280 | 347 | 470 | – | 263 | 262 | 354 | 478 | 27 | 27 | 95 | 62 | 90 | 118 | 169 | 166 | 125 | 13 | 35 | 41 |
| Endoplasmic Reticulum | 1 | 0 | 0 | 0 | 1 | 0 | 0 | – | 0 | 3 | 4 | 0 | 0 | 0 | 0 | 5 | 4 | 3 | 1 | 0 | 0 | 0 | 0 | 0 |
| Endosome | 0 | 1 | 2 | 2 | 1 | 3 | 5 | – | 0 | 0 | 0 | 1 | 0 | 0 | 1 | 4 | 5 | 8 | 2 | 2 | 1 | 0 | 0 | 0 |
| Golgi | 0 | 0 | 0 | 0 | 0 | 0 | 0 | – | 0 | 0 | 0 | 0 | 0 | 0 | 0 | 1 | 1 | 0 | 0 | 0 | 0 | 0 | 0 | 0 |
| Mitochondria | 20 | 2 | 1 | 5 | 1 | 40 | 48 | – | 90 | 64 | 206 | 126 | 2 | 0 | 0 | 4 | 1 | 1 | 17 | 7 | 14 | 0 | 0 | 1 |
| Nucleus | 15 | 19 | 14 | 26 | 17 | 16 | 14 | – | 6 | 7 | 9 | 3 | 3 | 3 | 9 | 24 | 29 | 19 | 30 | 35 | 22 | 5 | 2 | 3 |
| Nuclear Periphery | 0 | 0 | 0 | 0 | 0 | 0 | 0 | – | 0 | 1 | 1 | 0 | 0 | 0 | 0 | 0 | 0 | 0 | 0 | 0 | 0 | 0 | 0 | 0 |
| Nucleolus | 0 | 0 | 0 | 0 | 0 | 1 | 0 | – | 0 | 1 | 0 | 0 | 1 | 0 | 0 | 0 | 0 | 0 | 0 | 0 | 0 | 0 | 0 | 0 |
| Peroxisomes | 0 | 1 | 0 | 0 | 0 | 0 | 0 | – | 0 | 0 | 0 | 0 | 0 | 0 | 0 | 0 | 0 | 0 | 0 | 0 | 0 | 0 | 0 | 0 |
| SpindlePole | 1 | 1 | 1 | 1 | 1 | 5 | 12 | – | 8 | 6 | 8 | 15 | 0 | 0 | 0 | 0 | 2 | 0 | 6 | 1 | 1 | 0 | 1 | 0 |
| Vac/Vac Membrane | 29 | 34 | 9 | 9 | 28 | 16 | 12 | – | 7 | 10 | 5 | 12 | 4 | 0 | 5 | 70 | 64 | 88 | 16 | 18 | 20 | 1 | 3 | 4 |
| Unique Cell Count | 248 | 223 | 194 | 342 | 319 | 399 | 544 | 325 | 331 | 504 | 585 | 35 | 30 | 105 | 144 | 166 | 205 | 262 | 244 | 201 | 24 | 45 | 56 | |
| Labelled Cell Count | 267 | 240 | 199 | 354 | 336 | 436 | 582 | 388 | 370 | 605 | 658 | 37 | 30 | 110 | 172 | 199 | 238 | 262 | 244 | 201 | 24 | 45 | 56 | |
Yeast GFP Assignment
Protein Abundance
| Screen | WT1 | WT2 | WT3 | RAP60 | RAP140 | RAP220 | RAP300 | RAP380 | RAP460 | RAP540 | RAP620 | RAP700 | HU80 | HU120 | HU160 | rpd3Δ_1 | rpd3Δ_2 | rpd3Δ_3 | AF100 | AF140 | AF180 |
|---|---|---|---|---|---|---|---|---|---|---|---|---|---|---|---|---|---|---|---|---|---|
| Mean Cell GFP Intensity (1e-4) | 4.0 | 4.9 | 5.5 | 4.9 | 5.3 | 5.1 | 4.4 | – | 3.9 | 3.9 | 3.4 | 3.6 | 4.5 | 5.3 | 6.8 | 8.7 | 8.8 | 8.4 | – | – | – |
| Std Deviation (1e-4) | 2.0 | 1.5 | 3.8 | 1.5 | 1.4 | 13.1 | 1.3 | – | 5.7 | 1.3 | 1.0 | 1.0 | 1.1 | 1.8 | 10.6 | 3.0 | 3.6 | 2.8 | – | – | – |
| Intensity Change (Log2) | – | – | – | -0.15 | -0.05 | -0.11 | -0.32 | – | -0.49 | -0.49 | -0.7 | -0.61 | -0.29 | -0.04 | 0.31 | 0.66 | 0.68 | 0.61 | – | – | – |
Localization Change
| Localization | RAP60 | RAP140 | RAP220 | RAP300 | RAP380 | RAP460 | RAP540 | RAP620 | RAP700 | HU80 | HU120 | HU160 | rpd3Δ_1 | rpd3Δ_2 | rpd3Δ_3 |
|---|---|---|---|---|---|---|---|---|---|---|---|---|---|---|---|
| Cortical Patches | 0 | 0 | 0 | 0 | – | 0 | 0 | 0 | 0 | 0 | 0 | 0 | 0 | 0 | 0 |
| Bud | 0 | 0 | 0 | 0 | – | 0 | 0 | 0 | 0 | 0 | 0 | 0 | 0 | 0 | 0 |
| Bud Neck | 0 | 0 | 0 | 0 | – | 0 | 0 | 0 | 0 | 0 | 0 | 0 | 0 | 0 | 0 |
| Bud Site | 0 | 0 | 0 | 0 | – | 0 | 0 | 0 | 0 | 0 | 0 | 0 | 0 | 0 | 0 |
| Cell Periphery | 0 | 0 | 0 | 0 | – | 0 | 0 | 0 | 0 | 0 | 0 | 0 | 0 | 0 | 0 |
| Cytoplasm | 0.4 | 0 | -0.2 | -0.4 | – | -2.0 | -2.5 | -4.8 | -1.9 | -1.6 | 0.4 | 0.7 | -8.7 | -7.1 | -6.7 |
| Endoplasmic Reticulum | 0 | 0 | 0 | 0 | – | 0 | 0 | 0 | 0 | 0 | 0 | 0 | 0 | 0 | 0 |
| Endosome | 0 | 0 | 0 | 0 | – | 0 | 0 | 0 | 0 | 0 | 0 | 0 | 0 | 0 | 0 |
| Golgi | 0 | 0 | 0 | 0 | – | 0 | 0 | 0 | 0 | 0 | 0 | 0 | 0 | 0 | 0 |
| Mitochondria | 0 | 0 | 4.3 | 0 | – | 0 | 0 | 0 | 0 | 0 | 0 | 0 | 0 | 0 | 0 |
| Nucleus | 0.2 | -0.9 | -1.7 | -2.9 | – | -3.1 | -2.9 | -3.6 | 0 | 0 | 0 | 0.4 | 2.7 | 3.0 | 0.7 |
| Nuclear Periphery | 0 | 0 | 0 | 0 | – | 0 | 0 | 0 | 0 | 0 | 0 | 0 | 0 | 0 | 0 |
| Nucleolus | 0 | 0 | 0 | 0 | – | 0 | 0 | 0 | 0 | 0 | 0 | 0 | 0 | 0 | 0 |
| Peroxisomes | 0 | 0 | 0 | 0 | – | 0 | 0 | 0 | 0 | 0 | 0 | 0 | 0 | 0 | 0 |
| SpindlePole | 0 | 0 | 0 | 0 | – | 0 | 0 | 0 | 0 | 0 | 0 | 0 | 0 | 0 | 0 |
| Vacuole | -1.2 | 1.8 | -0.4 | -1.8 | – | -1.6 | -1.0 | 0 | -1.9 | 0 | 0 | 0 | 9.4 | 8.0 | 8.9 |
External localization resources
Images






























Protein Concentration and Protein Localization Data
| R1 | R2 | R3 | ||||||||||||||||
|---|---|---|---|---|---|---|---|---|---|---|---|---|---|---|---|---|---|---|
| G1 Pre-START | G1 Post-START | S/G2 | Metaphase | Anaphase | Telophase | G1 Pre-START | G1 Post-START | S/G2 | Metaphase | Anaphase | Telophase | G1 Pre-START | G1 Post-START | S/G2 | Metaphase | Anaphase | Telophase | |
| Concentration | -0.6658 | -0.0589 | -0.2176 | -0.0511 | -0.8824 | -0.4051 | -0.2904 | -0.3157 | -0.3881 | -0.7067 | -1.1147 | -0.8973 | -1.1379 | -1.0205 | -1.2034 | -1.3497 | -0.6651 | -1.1315 |
| Actin | 0.0012 | 0.0004 | 0.0002 | 0.0001 | 0.0009 | 0.0007 | 0.0284 | 0.0001 | 0.0115 | 0.0003 | 0.0106 | 0.0016 | 0.0343 | 0.0001 | 0.0146 | 0.0495 | 0.0412 | 0.0074 |
| Bud | 0.0021 | 0.0007 | 0.0003 | 0.0012 | 0.0075 | 0.0007 | 0.0008 | 0.0007 | 0.0009 | 0.0002 | 0.0015 | 0.0032 | 0.0007 | 0.0005 | 0.0022 | 0.0002 | 0.0025 | 0.0003 |
| Bud Neck | 0.0006 | 0.0005 | 0.0002 | 0.0008 | 0.0016 | 0.0021 | 0.0051 | 0.0002 | 0.0008 | 0.0001 | 0.0018 | 0.0041 | 0.0039 | 0.0001 | 0.003 | 0.0003 | 0.0019 | 0.0092 |
| Bud Periphery | 0.0014 | 0.0011 | 0.0002 | 0.0016 | 0.0038 | 0.001 | 0.0016 | 0.0003 | 0.0013 | 0.0002 | 0.0018 | 0.0015 | 0.0017 | 0.0002 | 0.0015 | 0.0002 | 0.0054 | 0.0002 |
| Bud Site | 0.0029 | 0.0015 | 0.0021 | 0.0002 | 0.0038 | 0.0002 | 0.0045 | 0.0042 | 0.005 | 0.0008 | 0.0007 | 0.0003 | 0.0047 | 0.0038 | 0.0096 | 0.0004 | 0.0021 | 0.0002 |
| Cell Periphery | 0.0002 | 0.0001 | 0 | 0 | 0.0001 | 0 | 0.0002 | 0.0001 | 0.0003 | 0 | 0.0002 | 0.0002 | 0.0002 | 0.0001 | 0.0003 | 0.0001 | 0.0002 | 0.0001 |
| Cytoplasm | 0.0886 | 0.1502 | 0.0782 | 0.054 | 0.0982 | 0.1071 | 0.0488 | 0.0761 | 0.0805 | 0.0391 | 0.0821 | 0.1021 | 0.0513 | 0.1599 | 0.1218 | 0.203 | 0.1417 | 0.1784 |
| Cytoplasmic Foci | 0.0129 | 0.0119 | 0.0047 | 0.0033 | 0.0044 | 0.0108 | 0.0336 | 0.0013 | 0.0258 | 0.0076 | 0.0052 | 0.0164 | 0.0335 | 0.0051 | 0.0079 | 0.0064 | 0.0146 | 0.0188 |
| Eisosomes | 0.0002 | 0.0002 | 0.0001 | 0 | 0.0001 | 0.0001 | 0.0003 | 0.0001 | 0.0007 | 0.0001 | 0.0005 | 0.0001 | 0.0003 | 0.0001 | 0.0004 | 0.0006 | 0.0004 | 0.0001 |
| Endoplasmic Reticulum | 0.0015 | 0.0021 | 0.0011 | 0.0006 | 0.0012 | 0.0008 | 0.0031 | 0.0024 | 0.0009 | 0.0006 | 0.0033 | 0.001 | 0.0027 | 0.0012 | 0.0018 | 0.0008 | 0.004 | 0.0021 |
| Endosome | 0.0063 | 0.0017 | 0.0033 | 0.0007 | 0.0007 | 0.0014 | 0.0418 | 0.001 | 0.0186 | 0.0408 | 0.0243 | 0.0032 | 0.0119 | 0.0012 | 0.0051 | 0.001 | 0.0159 | 0.0029 |
| Golgi | 0.0009 | 0.0001 | 0.0001 | 0 | 0.0001 | 0.0001 | 0.0097 | 0 | 0.004 | 0.0084 | 0.0055 | 0.0004 | 0.0051 | 0 | 0.0015 | 0.0009 | 0.0107 | 0.001 |
| Lipid Particles | 0.0027 | 0.0003 | 0.0005 | 0.0001 | 0.0001 | 0.0004 | 0.0153 | 0.0001 | 0.0053 | 0.0014 | 0.0104 | 0.0011 | 0.0228 | 0.0001 | 0.002 | 0.0007 | 0.0094 | 0.0022 |
| Mitochondria | 0.0033 | 0.0005 | 0.0007 | 0.001 | 0.0004 | 0.0005 | 0.0082 | 0.0002 | 0.0079 | 0.0053 | 0.0787 | 0.0011 | 0.0022 | 0.0001 | 0.0014 | 0.001 | 0.0047 | 0.0004 |
| None | 0.7182 | 0.7015 | 0.7604 | 0.6903 | 0.7384 | 0.7223 | 0.6543 | 0.8397 | 0.737 | 0.7291 | 0.6892 | 0.7796 | 0.7423 | 0.7652 | 0.7219 | 0.7212 | 0.6762 | 0.6703 |
| Nuclear Periphery | 0.0056 | 0.0051 | 0.0039 | 0.0024 | 0.0016 | 0.0022 | 0.0201 | 0.0048 | 0.003 | 0.0026 | 0.0138 | 0.0026 | 0.0065 | 0.0013 | 0.0054 | 0.0008 | 0.0029 | 0.0035 |
| Nucleolus | 0.0024 | 0.0012 | 0.0014 | 0.0019 | 0.002 | 0.0019 | 0.0051 | 0.0007 | 0.0019 | 0.0012 | 0.0022 | 0.0025 | 0.0015 | 0.0003 | 0.0027 | 0.0002 | 0.0005 | 0.0011 |
| Nucleus | 0.1267 | 0.1051 | 0.1223 | 0.1847 | 0.1256 | 0.1247 | 0.0715 | 0.0658 | 0.0721 | 0.1485 | 0.0513 | 0.0489 | 0.034 | 0.0559 | 0.0771 | 0.0032 | 0.0479 | 0.0826 |
| Peroxisomes | 0.0056 | 0.0004 | 0.0002 | 0.0002 | 0.0002 | 0.0005 | 0.0167 | 0 | 0.0079 | 0.001 | 0.0023 | 0.0021 | 0.0278 | 0 | 0.0013 | 0.0008 | 0.0081 | 0.0007 |
| Punctate Nuclear | 0.0144 | 0.0128 | 0.0184 | 0.0558 | 0.0089 | 0.0219 | 0.0247 | 0.0015 | 0.0125 | 0.0094 | 0.0073 | 0.0265 | 0.0108 | 0.0028 | 0.0172 | 0.0083 | 0.0082 | 0.0177 |
| Vacuole | 0.0018 | 0.0022 | 0.0013 | 0.0009 | 0.0005 | 0.0005 | 0.0043 | 0.0007 | 0.0016 | 0.0023 | 0.004 | 0.0012 | 0.0012 | 0.0015 | 0.001 | 0.0003 | 0.0011 | 0.0007 |
| Vacuole Periphery | 0.0005 | 0.0004 | 0.0002 | 0.0003 | 0.0001 | 0.0001 | 0.0021 | 0.0001 | 0.0003 | 0.001 | 0.0034 | 0.0002 | 0.0005 | 0.0003 | 0.0003 | 0.0001 | 0.0005 | 0.0002 |
Sequencing Data
| R1 | R2 | |||||||||
|---|---|---|---|---|---|---|---|---|---|---|
| G1 Post-START | S/G2 | Metaphase | Anaphase | Telophase | G1 Post-START | S/G2 | Metaphase | Anaphase | Telophase | |
| Gene Expression | 462.3604 | 568.3905 | 805.9057 | 315.6437 | 532.252 | 579.4229 | 449.2968 | 441.59 | 608.1423 | 300.9746 |
| Translational Efficiency | 0.7196 | 0.6469 | 0.4844 | 1.3435 | 0.7045 | 0.6551 | 1.1218 | 1.5042 | 0.9541 | 1.4827 |
Hit Data
| Dataset | Hit |
|---|---|
| Protein Concentration | ✘ |
| Protein Localization | ✘ |
| Gene Expression | ✘ |
| Translational Efficiency | ✘ |
Endocytosis
| Temp | Actin Patch (Sac6-tdTomato) | Cortical Patch (Sla1-GFP) | Late Endosome (Snf7-GFP) | Vacuole (Vph1-GFP) |
|---|---|---|---|---|
| 37℃ | ||||
| RT |
Cell Cycle Omics
CYCLoPs (Pdc5-GFP)
| Gene / Allele | Actin Patch (Sac6-tdTomato) | Cortical Patch (Sla1-GFP) | Late Endosome (Snf7-GFP) | Vacuole (Sac6-tdTomato) |
|---|
| Gene | Images |
|---|
| Gene | Images |
|---|
Images are not yet available
Images are not yet available